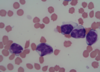
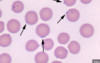
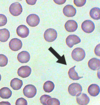
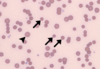

Describe the function of the spleen
- blood reserve (injury or exercise can release 10-20% BV)
- RBC metabolism
- hematopoesis (if BM fails can make RBC and WBC)
- immune function (macrophage pathogens and make antibodies)
What are the indications for a splenectomy
- trauma
- neoplasia (ie haemangiosarcoma)
- splenic torsion
What clinical signs may you see with hemangiosarcoma
- anaemia
- haemoabdomen
Is isolated splenic injury common?
No
Neoplasia in the spleen- total or partial splenectomy?
Total splenectomy
On US of the spleen you see a snow globe effect - what may has happened to the spleen?
Splenic torsion
What are the 2 main perioperative risks of splenectomy?
- DIC
- Increased risk of cardiac arrhythmis
Focal or benigh disease of the spleen- would you do a partial or total splenectomy?
Partial splenectomy
What are the 2 suture patterns used during a partial splenectomy?
2 rows of continuous overlappig mattress sutures followed by continuous suture / linear staple
What complications can be seen with splenectomy?
- Hemmorhage (due to technical failure)
- increased risk of infection
- cardiac arrhythmmias
- gastritis and pancreatitis (if you have compromised the left limb of pancreas’s blood supply)
What is the most common cause of thrombocytopenia?
Immune mediated thrombocytopenia
List causes of severe thrombocytopenia
- DIC
- immune mediated
List causes of mild thrombocytopenia
- hemmorhage
- splenic sequestration
- cavitated mass
Absence of all Vwf multimers- what type of Vwf disease is this?
Type 3
puppies usually die
Qualitative abnormalities in VwF structure and function. Decrease in large VwF multimers- what type of Vwf disease is this?
Type 2
All VwF multimers present but at decreased concentration- what type of Vwf disease is this?
Type 1
commonly seen in Dobermans
How to we test for VwF disease?
- Elisa (measure antibodies for VwF)
- immunoelectrophoresis
- genetic tests for carriers
Treatment for VwF disease
- cryoprecipitate
- desmopressin (prior to operations)
What clinical signs may you see with VwF disease?
- NO PETECHIA
- epistaxis
- mucosal bleeding
- bleeding may be absent
- PTT may be prolonger (factor 8)
- ## prolonged buccal mucosal time
If a patient has VwF disease will clotting times be normal or abnormal?
Normal
What part of the pathway does PTT measure?
intrinsic and common
What part of the pathway does ACT measure?
Intrinsic and common
What part of the pathway does PT measure?
extrinsic and common
what increases FDP?
- DIC
- hemmorhage
- jugular venous thrombosis
- liver disease